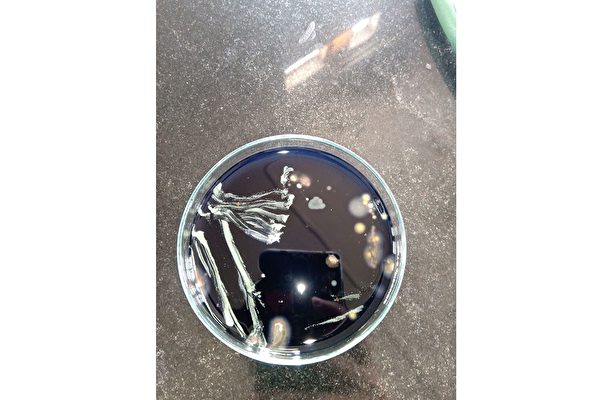

食物中毒可能是因为食物内含有细菌、病毒、或寄生虫,当这些病菌持续在肠胃道理作乱、生长,就会引发不适。另外,食物中毒

NASA 的“月球勘测轨道飞行器”(LRO)拍摄到的月球表面,可以看到圆圈所示的“蜘蛛”结构。(N
🔖
地震,
火山,
物理学,
陨石,
科学家,
卫星,
土壤,
蜘蛛,
行星,
月球,
岩浆,
重力,
月球土壤,

元朝皇帝陵墓从未被发现,主要是因蒙古人葬法太特殊,想要祭祖还得派出母骆驼。(示意图/shutter

出土仰韶文化中晚期的“双槐树遗址”,发现史前人已懂得粉刷墙壁,地板硬度竟与现代水泥差不多。

地震灾害真的这么可怕吗?综观 1900 年以来天然灾害事件的死亡人数排名,第一名的确不是地震灾害(根据统计资料,目
🔖
fda,
地震,
变异,
电磁,
磁场,
火山,
陨石,
科学家,
环境,
地球,
土壤,
自然灾害,
南亚大海啸,
板块,
岩石,

小麦与大麦起源于中东,稻米起源于长江流域,玉米起源于中美洲,这些是生物学家已经证实的农作物起源。但是你有没有想过,
🔖
病菌,
遗传,
科学家,
卫星,
环境,
土壤,
太阳,
植物,
生物学,
瘤,
降雨量,
氮,
山脉,

当秋风吹起,树木们便开始褪去辛苦制造养分的夏天之绿,露出隐藏在叶片之间的枝头。枫红可说是树木结束一年劳动后展开的庆

江苏连云港市一名男子平时喜欢摄影,一天路过社区池塘时,发现池里有动静,上前查看发现,里面竟有一只类似虾子的生物,长

位于大陆东北的辽宁省有一座奇山,因为百年来寸草不生,引发外界好奇,当地甚至流传一段乡野传说,认为底下埋着一位大人物

好奇号火星探测车于2022年5月7日在夏普山拍到的照片,其中可以看到一个门,看似一个通道的入口。(N

科学家们第一次用来自月球的土壤种出了地球植物。这是实现在月球上长期停留的重要一步。实验结果在《自然》
🔖
宇宙,
dna,
遗传,
进化,
火山,
细胞,
科学家,
宇航员,
登月计划,
环境,
地球,
基因,
土壤,
机器人,
太阳,
led,
机械,
植物,
月球,
外太空探索,
白鼠,
生物学,
瘤,
食物,
被子植物,
基因组,
岩石,
空间站,
阿波罗,
月球土壤,

太空人在国际太空站(International Space
Station)上执行任务通常需要几个月的时间,但
🔖
细菌,
科学家,
环境,
地球,
土壤,
植物,
流星,
太空船,
甲烷,
太空人,
大气层,
重力,
航空航天局,

新研究发现新西兰这片土地的下面有一块神秘的大陆,新西兰只是这块大陆露在海面上的一小部分。研究找到的土壤样品分析显示
🔖
科学家,
南极洲,
地球,
土壤,
岩浆,
花岗岩,
海水,
板块,
南极,
岩石,
分裂,
二氧化硅,

俄罗斯一组科学家最近成功地从西伯利亚的冻土里面,唤醒了2.4万年前的生物蛭形轮虫(bdelloid rotifer

科学家分析了来自南极洲两座山脉的土壤样品,第一次在地球上发现一些完全没有生命迹象的土地。这两座山脉位于南极洲的内陆
🔖
冰川,
细菌,
细胞,
科学家,
南极洲,
环境,
地球,
土壤,
微生物,
生物学,
直升机,
南极,
山脉,

英格兰多塞特郡(Dorset)一面山坡上有一个神秘的塞那阿巴斯巨人像(Cerne Abbas
Giant)。至

遍布全球的塑料污染是人类面临的一大难题。近几年科学家开发了一些可生物降解或可以作为土壤肥料的塑料来改善这个情况,但

在将来,某些金属的获取可能不需要通过采矿,而是仅通过种植就可实现。科学家发现了自然界中“超级蓄积”植物,它们可以生

火星表面经常会出现一些深色的纹路,持续一段时间以后消失,之后又再次出现。这种规律性的现象是火星上几个神秘的特征之一

象牙在古代极为罕见,若在遗址中挖出千根象牙,肯定非常不寻常。大陆考古学家曾在四川金沙村进行挖掘,出土大量金器、铜器

近些年人们发现树木的生长期似乎变成长了。欧洲多种知名的乔木春季发芽的时间比100年前平均提早了大约两周,而叶片在秋

火星的“盖尔撞击坑”(Gale Crater) 约40亿年前有各种无法想象的大小物,提升了这颗红色星球曾经存在生命的
🔖
彗星,
科学家,
卫星,
地球,
土壤,
行星,
二氧化碳,
微生物,
好奇号,
火星生命,
甲烷,

研究发现,奶酪独特的臭味原来是微生物之间对话的一种方式。谈话的内容很大程度上是在讨论为人类提供怎样的奶酪风味。

有人说,我们只是这个星球上的客人。因此我们应该像对待别人的家一样,以爱与尊重来对待它。“Loop”是一家位于荷兰代尔

近期一份研究在月球上发现了赤铁矿成分。科学家很好奇,月球那样基本没有空气、没有液态水的环境,怎么会生銹?
🔖
磁场,
科学家,
环境,
地球,
土壤,
行星,
太阳,
月球,
辐射,
太阳系,
大气层,
岩石,
月球土壤,

在非洲的纳米比亚的沿海沙漠中,有一种神奇的自然景象叫做“仙女圈”,从空中往下看,它就是一圈一圈的圆点。这个现象几乎

俄罗斯西伯利亚北极圈近年不断出现爆炸,栋土层被炸出一个大坑。
位处俄罗斯西伯利亚北极圈内

大自然往往充满了各种神奇和奥妙的事情,但它们有的时候需要被捕捉到才能让人们看到这些惊奇的画面。《Bright
Si
🔖
南极洲,
企鹅,
青蛙,
地球,
土壤,
UFO,
太阳,
植物,
野牛,
南极,

“火星大气如此稀薄,密度只有地球大气的1%。我们的设计所面临的第一个挑战就是飞行器必须足够轻盈能飞得动。”美国宇航

如果所有的病毒都消失了,世界将会大不相同。不一定会变得更好。但到底会发生什么呢?
病毒
🔖
癌症,
感染,
变异,
dna,
埃博拉病毒,
抗生素,
老鼠,
遗传,
进化,
细菌,
细胞,
科学家,
环境,
地球,
基因,
土壤,
微生物,
记忆,
植物,
黑死病,
生物学,
病毒,
瘤,
癌细胞,
食物,
疾病,
神经系统,
啮齿动物,
哺乳动物,
基因组,
噬菌体,

科学家发现,在厚厚的月球尘埃覆盖之下的次表面层,富含铁、钛这类金属。
7月1日发表在《地

研究人员表示,世界上最古老寺庙的庞大结构设计是根据对几何原理的理解而建造的,这很不寻常,因为普遍认为建造这座寺庙的

酸雨是空气中的酸性物质随雨水降至地表所造成的,而这些酸性物质有一部分源自于人类对环境的污染。现在,美国一项新的研究

2015年,国际空间站(ISS)的工作人员第一次吃到了在太空种植的生菜。今天的研究显示,在太空种植的生菜的营养和地面的

瘟疫,是对于具有传染力的疾病的通俗说法,“瘟,疫也。”在中国的史料中,很早就有关于“瘟疫”的记载。《黄帝内经》中就
🔖
感染,
梅毒,
病菌,
细菌,
细胞,
科学家,
环境,
土壤,
微生物,
黑死病,
结核病,
生物学,
疟疾,
疾病,
环游世界,

喜马拉雅山海拔4750米的碎石坡上可以看到盛开的冰川翠雀花
世界屋脊正在变绿?喜马拉雅山脉的雪峰,那些
🔖
冰川,
气候变化,
科学家,
卫星,
地球,
土壤,
植物,
伊丽莎白,
生物学,
雪,
降雨量,
喜马拉雅山,
珠穆朗玛峰,
山脉,

数百年来,复活节岛(Easter Island)上近千个巨大的摩艾石像和制作过程是一个令人惊叹的谜团。一份新研究发
🔖
香蕉,
火山,
火山口,
土壤,
植物,
雕像,

威斯康星大学麦迪逊分校(University of
Wisconsin-Madison)发表的一份研究显示,岩
🔖
斑马,
细菌,
细胞,
科学家,
青蛙,
环境,
地球,
土壤,
植物,
岩石,
分裂,
微观世界,

火星上是否宜居?是否存在生命?科学家们多年通过各种探索和测试,希望能找到答案。
自2012年降落在盖尔
🔖
陨石,
科学家,
探测器,
地球,
激光,
原子,
土壤,
行星,
机器人,
二氧化碳,
微生物,
好奇号,
空间科学,
氮,
甲烷,
火星探测,
岩石,

研究发现,植物根际土壤中的微菌成分对植株的抗病能力起到重要作用。这项结果为作物环保栽培开启了一扇全新的大门。 番茄和
🔖
感染,
细菌,
土壤,
微生物,
植物,
疾病,
一份新研究称,通过简单的基因编辑,能从土壤中发现多种全新的抗生素。在生物界已经几十年没实现抗生素的突破、超级细菌危机愈

英国伯克郡(Berkshire)一座村庄,考古学家发现一幅非常罕见的罗马马赛克画,早在公元前3000年,就已经有马

一份新研究显示,让身体短暂受压——比如蒸桑拿或跑步,有助于增加身体在遭受疾病袭击时的耐受力。
这份新研究发现在
🔖
大脑,
变异,
遗传,
细胞,
环境,
基因,
土壤,
长寿,
疾病,
跑步,
神经元,

2018年12月17号大事件: NASA的“洞察号”着陆舱在十天前着陆火星并提供了在这个红色的星
🔖
火山,
科学家,
卫星,
人造卫星,
地球,
恒星,
土壤,
行星,
二氧化碳,
太阳,
植物,
氮,
传感器,
沙尘暴,
洞察号,
大气层,
重力,

1969年7月20日,人类在月球上踩下了第一个足印。50年后的今天,人类已在规划踏足太阳系内其它星球甚至去银河系内
🔖
地震,
银河系,
磁场,
火山,
物理学,
科学家,
探测器,
宇航员,
环境,
地球,
激光,
土壤,
太阳,
月球,
辐射,
范艾伦辐射带,
火山喷发,
太阳系,
太阳能,
大气层,
岩石,
同位素,
阿波罗,

欧洲宇航局(ESA)的科学家们找到了利用月球土壤制成砖头储存热量的方法,在月球上长达16天的漫漫黑夜中为宇航员和勘

美国宇航局(NASA)将使用红外线相机,在人类再次登月之前描绘出一份最详细的月球地图。

目前除了各国政府都在规划发射载人太空船去月球外,一些私有财团也在计划。有的是为了展示实力,有的单纯为了搞研究,但是这
🔖
电池,
陨石,
氦,
探测器,
环境,
地球,
土壤,
太阳,
月球,
辐射,
太空船,
太阳能,
大气层,
质量,
同位素,
阿波罗,
月球土壤,

位于北极圈内的斯瓦巴群岛(Svalbard)是挪威最北端的领土,其首府朗伊尔城(Longyearbyen)地处北纬7

最新一份研究发现,1971年阿波罗14号登月采集并带回地球的月球表面的岩石样本,竟含有来自约40亿年前地球土壤的碎
🔖
宇宙,
陨石,
科学家,
卫星,
宇航员,
地球,
土壤,
行星,
月球,
生物学,
史前文明,
岩石,
阿波罗,

